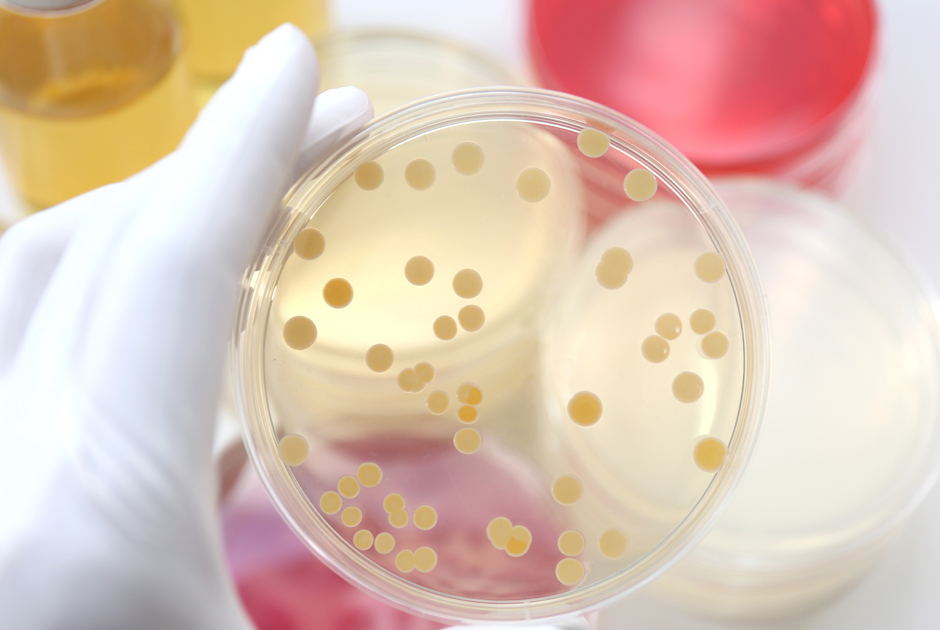

I & D
Los recubrimientos de quesos de Becor Barbanza son el resultado de la I+D realizada en los últimos años por la empresa en un amplio grupo de proyectos de investigación que han sido financiados por la Unión Europea y los programas sectoriales de la Xunta de Galicia.
Esta nueva tecnología ha permitido producir un grupo de recubrimientos de quesos para la protección de la superficie frente al crecimiento de los hongos. La base de esta tecnología está en las mezclas y el entrecruzamiento molecular de los biopolímeros naturales que se disuelven en agua. Estos biopolímeros son los mismos que se utilizan ampliamente en alimentación.
Los biopolímeros mezclados con otros productos naturales, producen una película sobre el queso que ajusta su exudación e impide el crecimiento de los hongos. Esta tecnología es el soporte de los recubrimientos Riocobert y Natricobert. Estos son los únicos recubrimientos de quesos del mundo que se pueden comer.
Los biopolímeros también actúan como soporte y liberación controlada del antifúngico natamicina para impedir el crecimiento de los hongos. Para las necesidades de recubrimientos para condiciones ambientales más drásticas para los quesos, se han desarrollado Riocobert y Riocobert Plus.
El uso de tecnologías de medida espectrofotométricas, cromatografía de HPLC, cromatografía de GCMasas, IPC-Masas, ultrafiltración, microbiología y microencapsulación, han permitido el desarrollo de estos productos de última generación.